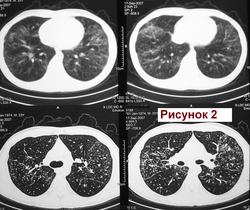

Пол пациента:
Тип патологии:
Область исследования:
Муж.1974 г. р. Изменения впервые выявлены при проверочной флюорографии 2007 (Рис.1). Выполнена КТ легких (См фрагмент. Рис.2). Исчез. Продолжал работать. Не лечился. Пришел на обследование в 11.2011г. с жалобами на покашливание. Температура, кровь: норма. (Рис.3). О какой патологии легких можно думать? Я предположил саркоидоз. Специалистов по КТ очень прошу разъяснить рисунок 2. С уважением Nik.

Где работает пациент?
Больше данных за саркоидоз. Кем работает?
Медиастинально-легочная форма саркоидоза.
Болезни ног: виды, симптомы, причины, профилактика и лечение
Вопрос профессии, на мой взгляд краеугольный, так как на 1 место в ряду в "одной весовой категории" выходят - пневмокониоз и саркоидоз. Конечно, уважаемый Nikolas, на очень структурном снимке ОГК, произведенном на микрофокусе, или на очень качественной томограмме, можно различить, ту, диагностически благодатную "сеточку", которая бывает даже в "предстадии" силикоза (пневмокониоза). А, следовательно, где и кем работает, вопрос остается.
Конечно, по первому снимку и по КТ "Его Величество" полностью не отметается, так сказать, ожидает в "диагностической заначке"...
Инженер программист. Много работает. Лечиться "ему некогда". Направлен был на дообследование. У врача не появляется. Информация получена сегодня от врача поликлиники. О наличии результатов исседования обязательно сообщу. Жду квалифицированое заключение врачей КТ -шников. Ау-уууу! Где Вы, друзья специалисты по КТ? С уважением Nikolas
По имеющимся картинкам предположила бы саркоидоз, но помимо ретикулярного и узелкового паттерна по фото КТ-плёнки, могут быть и другие изменения на оригинале (dicom-файлы). Диф.ряд тут:
http://www.radiomed.ru/publications/luchevaya-diagnostika-diffuznykh-interstitsialnykh-zabolevanii-legkikh-dizl-obshchie--0
https://www.youtube.com/channel/UCBGxoBUOqUT_bFhSeUgtWEw
Интерстициальные заболевания легких. Был случай у 20 летнего парня, начинался с таких же изменений в легких, закончился ЛГМ. Правда через три года в легких были округлые очаги.
Пациент обследован. Диагноз саркоидоз органов дыхания подтвержден. Спасибо. С уважением к Вам Nikolas
Cпасибо, коллега Nikolas, что как всегда, свои презентации доводите до логического конца- подтверждения диагноза!